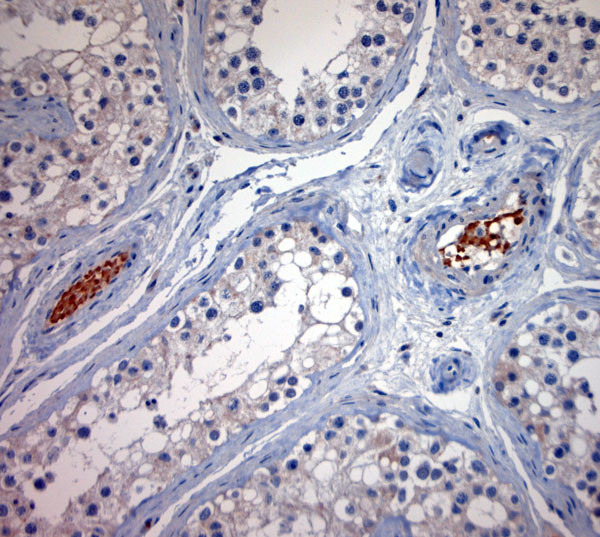
BBS2 Antibody in Immunohistochemistry (Paraffin) (IHC (P))

Search
Osenses
BBS2 Polyclonal Antibody
{{$productOrderCtrl.translations['antibody.pdp.commerceCard.promotion.promotions']}}
{{$productOrderCtrl.translations['antibody.pdp.commerceCard.promotion.viewpromo']}}
{{$productOrderCtrl.translations['antibody.pdp.commerceCard.promotion.promocode']}}: {{promo.promoCode}} {{promo.promoTitle}} {{promo.promoDescription}}. {{$productOrderCtrl.translations['antibody.pdp.commerceCard.promotion.learnmore']}}
图: 1 / 5
BBS2 Antibody (OSB00030W-100UL) in IHC (P)





产品信息
OSB00030W-100UL
种属反应
宿主/亚型
分类
类型
抗原
偶联物
形式
浓度
保存液
内含物
保存条件
运输条件
产品详细信息
Reconstitute in 100 µL of sterile water. Centrifuge to remove any insoluble material.
The peptide is homologous in rat and mouse.
Specificity of this antibody: BBS2.
靶标信息
This gene is a member of the Bardet-Biedl syndrome (BBS) gene family. Bardet-Biedl syndrome is an autosomal recessive disorder characterized by severe pigmentary retinopathy, obesity, polydactyly, renal malformation and mental retardation. The proteins encoded by BBS gene family members are structurally diverse and the similar phenotypes exhibited by mutations in BBS gene family members is likely due to their shared roles in cilia formation and function. Many BBS proteins localize to the basal bodies, ciliary axonemes, and pericentriolar regions of cells. BBS proteins may also be involved in intracellular trafficking via microtubule-related transport. The protein encoded by this gene forms a multiprotein BBSome complex with six other BBS proteins.
仅用于科研。不用于诊断过程。未经明确授权不得转售。
生物信息学
蛋白别名: Bardet-Biedl syndrome 2 homolog; Bardet-Biedl syndrome 2 protein; Bardet-Biedl syndrome 2 protein homolog; BBSome complex member BBS2; MGC20703; unnamed protein product
基因别名: 2410125H22Rik; AI447581; BBS; BBS2; RP74
UniProt ID: (Human) Q9BXC9, (Rat) Q99MH9, (Mouse) Q9CWF6
Entrez Gene ID: (Human) 583, (Rat) 113948, (Mouse) 67378